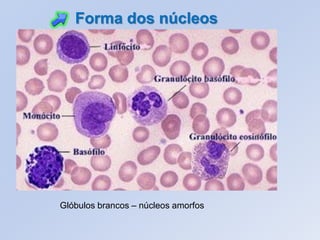
Glóbulos brancos – núcleos amorfos
Forma dos núcleos

O documento descreve as principais características do núcleo celular, incluindo sua estrutura, componentes e funções. O núcleo contém o material genético da célula e controla suas atividades através da cromatina e dos genes nela contidos. Experimentos históricos demonstraram que o núcleo é essencial para o controle das funções celulares.